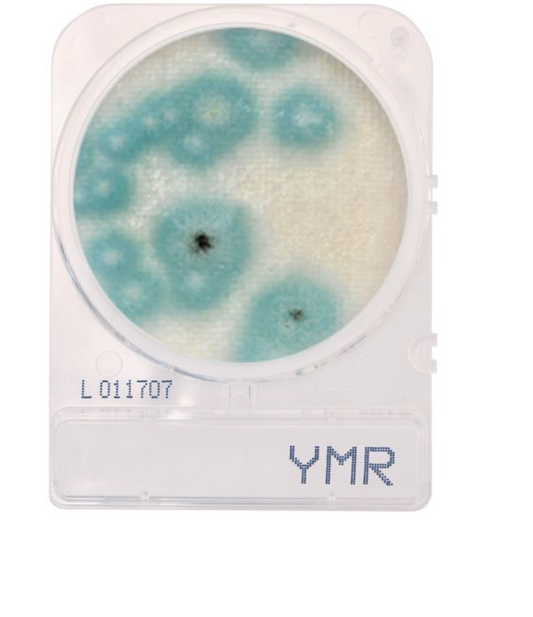
CompactDry™ Yeast/Mold Rapid (YMR) for colony counts, 60pkgs of 4 plates

-
Potato Dextrose Agar (PDA), USP, for fungal cultures, Deep Fill, 15x100mm Plate. 10 Plates
Regular price $22.51 USDRegular priceUnit price / per -
Tryptic Soy Agar (TSA), USP. PACK SIZE: 10 per package, 100 per case
Regular price $145.42 USDRegular priceUnit price / per -
Tryptic Soy Broth (TSB), USP, 500mL Fill, Polycarbonate Bottle
Regular price $30.24 USDRegular priceUnit price / per -

Tryptic Soy Broth (TSB) with Lecithin and Tween 80, 500mL Fill, Polypropylene Bottle. 10 per package
Regular price $207.98 USDRegular priceUnit price / per -
Tryptic Soy Broth (TSB), USP, Double Strength, 100ml Fill, Polycarbonate Bottle, 12 per package
Regular price $197.22 USDRegular priceUnit price / per -
CompactDry™ Yeast/Mold Rapid (YMR) for colony counts, 60pkgs of 4 plates
Regular price $299.80 USDRegular priceUnit price / per -
Hardy Diagnostics W390 – SterEM™ R2A Agar, Irradiated Settle Plate (15×100 mm, Triple-Bagged), 10 plates
Regular price $72.43 USDRegular priceUnit price / per -
Standard Methods Agar (SMA), Plate Count Agar, 15x100mm Plate
Regular price $16.79 USDRegular priceUnit price / per -
Hardy Diagnostics P99 Contact Plate – D/E (Dey-Engley) Neutralizing Agar, Non-Irradiated (Broad-Spectrum Neutralization), USP 797, 10 Plates
Regular price $76.95 USDRegular priceUnit price / per -
Sterile Deionized Water, 100mL Fill, Polypropylene Bottle
Regular price $107.20 USDRegular priceUnit price / per -
Butterfield's Phosphate Buffer, 100mL Fill, Polypropylene Bottle
Regular price $134.12 USDRegular priceUnit price / per -
Tryptic Soy Broth (TSB), USP, 500mL Fill, Glass Bottle with Screw-cap Needle-Port Septum
Regular price $659.26 USDRegular priceUnit price / per -
Buffered Peptone Water (BPW), 400mL Fill, Polycarbonate Bottle
Regular price $249.69 USDRegular priceUnit price / per -
Phosphate Buffered Saline (PBS), pH 7.5, 1000mL Fill, Polycarbonate Bottle
Regular price $320.13 USDRegular priceUnit price / per -
Buffered Peptone Water, 10mL
Regular price $152.01 USDRegular priceUnit price / per -
Tryptic Soy Broth (TSB), USP, 1000mL Fill, Polycarbonate Bottle, 10 per package
Regular price $401.53 USDRegular priceUnit price / per -
Potato Dextrose Agar (PDA) with Chloramphenicol, Deep Fill, 15x100mm Plate
Regular price $202.24 USDRegular priceUnit price / per -
Potato Dextrose Agar (PDA) with Chlortetracycline, 15x100mm Plate
Regular price $31.12 USDRegular priceUnit price / per -
Sabouraud Dextrose Agar (SabDex) Agar, USP, Blue Tinted Media, 15x100mm Plate
Regular price $19.25 USDRegular priceUnit price / per -
Malt Extract Agar with Chloramphenicol, 15x100mm Plate
Regular price $18.36 USDRegular priceUnit price / per -
Sabouraud Dextrose Agar (SabDex) with Chloramphenicol, 26mL Fill, 15x100mm Plate
Regular price $25.65 USDRegular priceUnit price / per -
Czapek Yeast Agar Plate, Deep Fill, 15x100mm
Regular price $83.71 USDRegular priceUnit price / per -
Tryptic Soy Agar (TSA), 15x60mm Plate
Regular price $34.23 USDRegular priceUnit price / per -
Inoculation spreader, L-Shaped, STERILE, PS, Individually Wrapped
Regular price $44.69 USDRegular priceUnit price / per -
SporAmpule® Liquid Biological Indicator, for Steam Sterilization. 20/box
Regular price $89.56 USDRegular priceUnit price / per -
SporeView Bio-Indicator for Steam, Dry Heat, and EO Gas Sterilization. 100/box
Regular price $462.00 USDRegular priceUnit price / per -
Hardy Diagnostics P36 Contact Plate – Sabouraud Dextrose Agar (SabDex), Non-Irradiated, (No Neutralizers), USP 797, 10 Plates
Regular price $41.79 USDRegular priceUnit price / per -
Hardy Diagnostics P93 Contact Plate – Malt Extract Agar (MEA) w/ Lecithin & Tween, Non-Irradiated (Fungal Monitoring), USP 797, 10 Plates
Regular price $82.29 USDRegular priceUnit price / per -

Hardy Diagnostics W70 – Sabouraud Dextrose Agar (SabDex), Settle Plate (15×100 mm, 26 mL), 10 plates
Regular price $15.37 USDRegular priceUnit price / per -
Hardy Diagnostics G60 – Tryptic Soy Agar (TSA) Settle Plate, Sterile (Non-Irradiated), 10 plates
Regular price $14.64 USDRegular priceUnit price / per -
SterEM Tryptic Soy Agar (TSA), IRRADIATED, USP, Triple Bagged, 34mL Deep Fill
Regular price $45.17 USDRegular priceUnit price / per -
Hardy Diagnostics W370 – SterEM™ Sabouraud Dextrose Agar (SabDex), Irradiated Settle Plate (15×100 mm, Triple-Bagged), 10 plates
Regular price $72.03 USDRegular priceUnit price / per